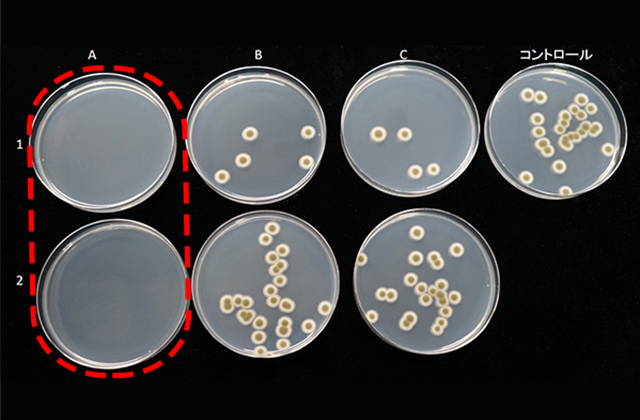
Aが開発した防カビコート剤　お風呂によく生える黒カビの一種「クラドスポリウム」

水まわりのお掃除
おそうじ本舗 浴室の「防カビコート」開発
おそうじ本舗の尾崎です。
突然ですが、皆さん「おそうじで一番の悩み」は何ですか?人によってそれぞれ…ですよね。
実は、おそうじ本舗に寄せられる注文・相談内容の1位はエアコン、2位は浴室なのですが、どちらにも共通するのが「カビ」です。
今回は、浴室用の「防カビコート」の開発までの経緯やポイント、サービスの詳細についてご紹介します。

目 次
開発① 誰もが悩む「カビ」とこれまでのサービス
エアコンは、「防カビチタンコーティング」というサービスがあるのに浴室にはなぜ「防カビサービス」がないのか?と、幾度となく聞かれることはありましたが、これまでサービス化に踏み切ることはありませんでした。
何故でしょうか?
世の中には防カビ剤が沢山あります。しかし浴室は毎日大量のお湯や水を使ったり、おそうじでゴシゴシこすったりするので、中途半端に防カビ剤を塗っても取れてしまい、効果があまり長期間持たないのです。

おそうじ本舗のエアコンクリーニングで採用している「防カビチタンコーティング剤」。これも無光触媒という特殊な液剤で非常に効果が高く値段も高価ですが、エプロン内部のような湿気は多いけれど水があまりかからない場所に使用するのには適していても、毎日大量のお湯や水がかかる浴槽内や床などに使用するには耐久性が低く不向きです。
そんなこともあり当社では10年以上前から、浴室をクリーニングした後に下地処理を行い、浴室全体に強靭なコーティング剤を塗ることで、新築のような輝きを取り戻しつつ汚れやカビが直接つかなくしてしまう「浴室コーティング」というサービスを開発してきました。

水垢が固くこびりついた浴槽が、つやつやの新品のように
このサービスは主に新築の時や、中古物件を買ったお客様に非常に好評をいただいております。自信をもって進められるサービスですが、浴室コーティングは状態にもよりますが下処理清掃から施工まで一式で約7~8万円くらいの費用がかかります。
「中途半端なサービスはしたくない」
そんな、我々おそうじのプロフェッショナルとして妥協したくないという強い思いから、ハウスクリーニングのオプションサービスという位置付けでは、これまでサービス化しなかったのです。
しかし、数年前から、たとえ数か月しか持たなくても少しでもカビの繁殖がおさえられるなら…ということで、市販品の防カビ燻煙剤が飛ぶように売れ始めました。
我々おそうじのプロフェッショナルができることは、8万円のコーティング以外にも何かあるのではないか?
いや、必ずある!居ても立っても居られない状態になってしまい、とりあえず日本中の防カビ剤を取り寄せて調べることにしました。
開発② 防カビ剤開発スタート!まずは自宅でカビ飼育
私、尾崎は自宅の浴室でカビを培養していたりします。(家族にはすこぶる不評ですが…)

また、カビの生えやすい箇所はあえて半分しか掃除せず、どれくらいで再び生え始めるか調べたりしています。(こちらも家族にすこぶる不評…)
最新式のお掃除機能が付いたエアコンを購入するも、あえて2年間何もせずに汚れ具合を観察したり…何でこんなことをしているのかというと、洗剤や除菌剤などのテストがいつでもできる万全の環境を自宅で整えているのです。
自宅には、よく解らない怪しげな液剤や見たことのない掃除道具をちょくちょく持ち込んで収納や倉庫を占拠してしまうので、理解ある家族の対応には本当に感謝しています(笑)

怪しげな液剤たち
毎月、私の元には国内外の様々なメーカーから最新の洗剤や清掃機材などが送られてきます。
またアポイントの営業もひっきりなしに来ます。理由は簡単。チェーンとして公式採用すれば1700以上の店舗が全国で使い始めるので、ものすごい勢いで発注する事になります。
ただ、それだけ採用する側の責任も重いので、現場テストも十分に行いつつ、自宅でもテストをしたいのです。とにかく、清掃に関する日本最新のノウハウは私の所に集まってきます。
そして私には一年中カビを研究している、千葉大学の矢口先生という強い味方が。
「そうだ! 千葉に行こう!」
開発③ カビ専門機関の試験結果
防カビ剤を開発すること、おそうじ本舗でサービス化することを決めた私は、千葉大学に来ていました。かねてから交流のある千葉大学真菌医学研究センター准教授の矢口先生に思いのたけをぶつけたところ、

「とても良い取り組みですね。私にできることは協力します!」
との事で、テストの検証方法など決めていくことになりました。
矢口先生、いつもありがとうございます!
おそうじ本舗 近畿地域本部のメンバーにテストピースを何百と作ってもらったり、日本一カビの多い地域、沖縄県メンバーにテスト協力してもらったり。いろんな関係者に協力してもらいながら、約半年で防カビコート剤が完成しました。
防カビコート剤試験結果
Aが開発した防カビコート剤 お風呂によく生える黒カビの一種「クラドスポリウム」

こちらもお風呂によくあらわれる、ピンク色の酵母菌の一種「ロドトルラ」
テストピースを、市販の浴室洗剤に浸け込んでも、そのあと擦って防カビコートの被膜を傷つけても、他の防カビ剤に比べて圧倒的な防カビ効果を出してくれています。
開発④ サービス開発のポイント
サービス開発でこだわったのは、お風呂によく生えるカビに対して、防カビ効果が長く続き、カビ掃除が大変な場所に効果があること。
1)カビの種類
カビの種類は何万とある中、今回開発したおそうじ本舗の「防カビコート剤」は、特に浴室に多いカビに特化して開発しました。ひとつは、赤カビ・ピンクカビ・赤いぬめりとして認識されている「ロドトルラ」。湿気を好み、お風呂や洗面所など水回りに多くみられるカビです。

汚れの原因となり、放置すると「掃除さぼっている感」が出てしまうので、精神的なストレスにもなりがちです。
もうひとつは、お風呂に多い黒カビの一種「クラドスポリウム」。

ゴムパッキンやタイルの目地に生える黒カビの主な原因がこのクラドスポリウムです。
吸いすぎると、呼吸器系アレルギーの原因になる可能性があると考えられています。
どちらも、お掃除が面倒・やっかいなカビとして、皆さんも認識されているのではないでしょうか?防カビ成分の配合やその試験は、この2つのカビ対策を中心に開発しました。
2)防カビ効果の持続性
単なる液剤では普段の生活で水を使った場所はすぐに防カビ成分が流れてしまいますが、今回開発した防カビコート剤は防カビ効果が約3か月持続します(※1)。
(※1)使用環境などによって期間は変動する可能性があります。※全てのカビの発生・繁殖を防ぐものではありません。
検体には、市販の浴室用洗剤に浸したり、一般的な掃除の状況を想定した試験方法で、防カビ効果を検証しました。

防カビコート剤を塗布した検体を市販の浴室用洗剤に浸漬した様子

Aがおそうじ本舗の防カビコート剤、B・Cは市販の防カビ剤で比較
ロドトルラ(一般的に赤カビ・赤いヌメリとして認識されるカビ)

(※2)千葉大学 真菌医学研究センターによる試験
(※2)理論的には2×103個滴下し、生育してきたコロニー数 シャーレ3枚の平均値を10倍
クラドスポリウム(一般的に黒カビとして認識されるカビ)

(※3)千葉大学 真菌医学研究センターによる試験
(※3)理論的には1.5×103個滴下し、生育してきたコロニー数 シャーレ3枚の平均値を10倍
【試験方法】
各検体を市販の浴室用洗剤(10倍希釈)に1日浸漬、ティッシュでふき取り、綿棒で30回こする。滅菌水で30秒攪拌、1時間浸漬し、ティッシュでふき取る(①)。硬い紙で30回こする(②)。各検体にロドトルラ、クラドスポリウムの菌液を滴下。3日間、25℃で放置。各検体を滅菌水3mlで洗い出し2日間培養。
3)施工場所
施工場所は、ご家庭で掃除するのが大変な場所、カビが生えるとなかなか落ちない場所に設定しました。
天井

お風呂の天井は高いので手が届きにくい場所。しかも、お風呂に発生するカビの原因は天井のカビともいわれています。他の場所に比べてカビの栄養分は少なめですが、水分がつきやすく、手も届きにくいためカビが生えやすいのが天井です。
お風呂のカビ対策にはマストな場所ですね。
エンボス壁面・アクリル扉

素材の表面に細かな凹凸があると、汚れや水分がひっかかりやすくなります。
そんな場所は、気づかぬうちに汚れがたまっていて、そこからカビが生えることも。
エンボスになっていることで汚れを見落としがちだからこそ、防カビ対策しておきたい場所です。
ゴムパッキン・ゴム素材

パッキンは黒カビが生えやすく、カビ取り剤を使ってもとれないというお客様や、またテレビ等の取材でもお悩みを多くいただきます。
プロは業務用の洗剤や器材を使って黒カビを落としますが、お家ではなかなかそこまできれいになりません。そんな場所だからこそ、プロがきれいにしたあとは、できるだけ長く維持できるようにと、施工場所に設定しました。
まとめ
というわけで、原料メーカーさんや検査機関、一部お客様などに協力いただき、サービスを世に送り出すことができました。本当にありがとうございます!
今後もお客様やスタッフの声を聞きながら、より喜んでいただけるサービスにしていきたいと思います。ぜひ、多くの方にお試しいただき、清潔なお風呂を維持できる生活を実感していただきたいです!
おそうじ本舗の「浴室防カビコート」でカビ予防!

浴室をきれいにお掃除していても、カビは生えてきてしまいます。
浴室のカビにお悩みでしたら、ぜひおそうじ本舗の浴室クリーニング(※5)のオプション「浴室防カビコート(※4)」をお試しください。
浴室クリーニング(※5)で浴室のカビや水アカなどの汚れをきれいに落とした後、「浴室防カビコート(※4)」を施工することで、カビを生えにくくしてきれいな状態を長くキープします。
おそうじ本舗が独自開発した防カビコート剤は、浴室に多い黒カビ(クラドスポリウム)や赤いヌメリ(ロドトルラ)に特化しているので、高い防カビ効果が期待できます。
カビが生えやすいゴムパッキンや目地、天井や見逃しがちなドアにも施工でき、約3か月カビを予防します(※4)。
(※4)使用状況により浴室防カビコートの効果期間は異なります。全てのカビを抑制することを保証するものではありません。
(※5)汚れの状況により、完全に除去できない場合がございます。
この記事の監修者
ハウスクリーニング商品開発尾崎 真
おそうじ本舗の商品・サービス開発責任者を務め、国家資格であるハウスクリーニング技能士。 住まいのお掃除のコツや、暮らしに関するテクニックなど、お家で役立つ情報について満足していただける内容の改修を行っています。
おそうじ本舗 自分でできるお掃除術 監修者について

